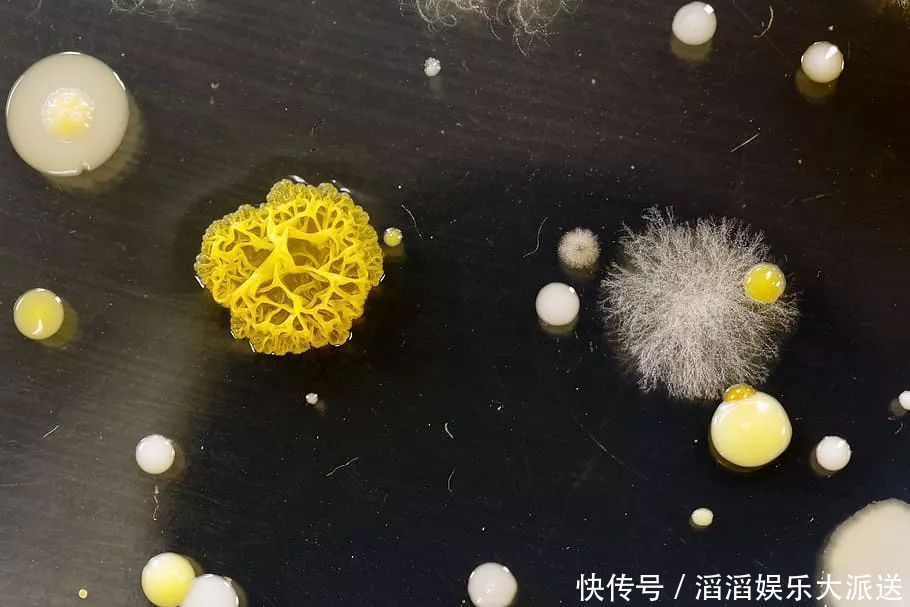
感冒|一场小感冒花了31万?孩子经常用的这种药,危害有多大?

感冒|一场小感冒花了31万?孩子经常用的这种药,危害有多大?
最近兜妈看到一则新闻,真是可怕,四川省一个高二少年小罗(化名),因为一场感冒住进了重症病房,并且在半月里花费了近31万的医疗费用。起初小罗打电话告诉父母,自己只是得了一场小感冒,小罗的父母以为只是小毛病、问题不大。

文章插图
第二天,他们就接到了小罗班主任的电话,被告知小罗已经住进了重症监护室。家长赶紧坐飞机回到老家,却发现小罗身上插满了管子,在病床上昏迷不醒。

文章插图
前一天还活蹦乱跳,第二天就人事不省,小小的感冒竟有如此威力,能引发这般严重的后果?根据医院的医生介绍,原来小罗不仅得了感冒,而且感染上了MRSA超级细菌,而这种细菌其实并不稀奇,每个人都有可能遇到……超级细菌是什么超级细菌不是特指某一种细菌,而是泛指那些对多种抗生素具有耐药性的细菌,又称“多重耐药性细菌”。超级细菌的品类繁多,常见的有耐甲氧西林金黄色葡萄球菌(MRSA)、万古霉素肠球菌(VRE)、多重耐药性结核杆菌(MDR-TB)等。
文章插图
这类细菌能对抗生素有强大的抵抗作用,能逃避被其杀灭的危险。那么这些细菌究竟从何而来呢?基因突变是这些细菌产生的根本原因,但临床上抗生素的广泛应用使得这一进程进一步加快。可以说,超级细菌是人类用抗生素喂养出来的!我国普遍存在抗生素的滥用,这使得抗菌药物和细菌耐药性之间的平衡被破坏。具有耐药能力的细菌通过不断的进化与变异,获得针对不同抗菌药物耐药的能力,这种能力在斗争中不断强化。细菌逐步从单一耐药到多重耐药甚至泛耐药,最终成为耐药超级细菌。

文章插图
滥用抗生素的危害其实,滥用抗生素,除了能够使细菌加速获得耐药性,变成超级细菌外,还能造成诸多其它恶果:1. 破坏体内菌群平衡,使免疫力降低过多使用抗生素,不仅会杀害体内的致病菌,同时也会杀灭部分人体内的其它菌群。例如人体的肠道菌群,便是由多种细菌合理配比,相互依存相互制约形成的动态平衡。如果人体使用太多的抗生素,导致一些敏感菌死亡,而其他菌种相对过多繁殖,便会造成菌群失调,从而导致人体营养吸收不均,抵抗力随之下降。

文章插图
2. 具有毒副作用,严重者可损害儿童听力是药三分毒,根据研究,不同品类的抗生素能够对人体造成不同的毒副作用。例如链霉菌便可能引起眩晕、耳鸣等症状;而庆大霉素、万古霉素则会损害肾脏等器官。特别值得注意的是,耳朵对抗生素的副作用最为敏感,多种抗生素都有可能影响耳朵的毛细胞,而使人体的听力下降。对于儿童来说,正处于身体的生长期,抗生素对其听力的影响则会更为严重。

文章插图
3. 药物效果打折,未来无药可用由于抗生素的大量使用,许多细菌都在与抗生素的斗争中获得了抗药基因。随着越来越多的超级细菌的产生,未来能够治愈细菌感染的药品种类则会越来越少,甚至可能陷入无药可用的困境。4. 引起严重过敏,可导致休克死亡在临床医疗中,抗生素过敏是一种极为严重的过敏反应。病人常常表现出皮疹,然后心慌、胸闷、出冷汗、血压降低,甚至出现过敏性休克,严重的可能导致死亡。
- 小时候过新年穿新衣,现在新年你们会给孩子准备特别的仪式感吗?
- 奶奶|7个月小屁孩坐在地上跟奶奶吵架,接下来动作,太可爱了!
- 重复率|90后小夫妻的结婚证火了,看到上面的名字后,网友:孩子叫什么?
- 小天使|“女巨婴”:16岁了吃饭还靠妈喂,每日花销过万,她的现状怎样?
- 倾城亦清欢|《倾城亦清欢》是根据什么小说改编的 倾城亦清欢原著小说结局是什么
- 孩子|一行字写3小时,美国爸爸辅导孩子气到崩溃,网友:崩溃不分国界
- 小蝌蚪|同样是50岁,为啥有些人还能生,有些人却不行?夫妻俩谁的问题?
- 奥数|8岁智商高达146!“天才儿童”从小就有以下特征,你家娃满足几个
- 轻轻拍打屁股其实不算很疼,为什么小孩子哭那么厉害?
- 小王子|成功顺产小王子!症状附上,喜欢男孩的孕妈来接走,都能如愿!